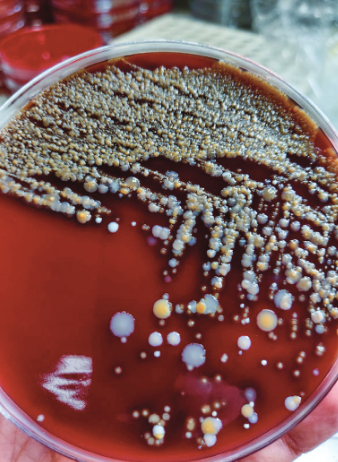
Human Spaceflight tweet media

Tweet épinglé

We're striking the heart of the matter - with a 3D bioprinter, a miniature heart, a microfluidic chip and Space.
With AstroCardia, our latest research project, we look at a microscopic level at what happens to our heart as we age. 👨🔬👵
Explore more: astrocardia.com

English